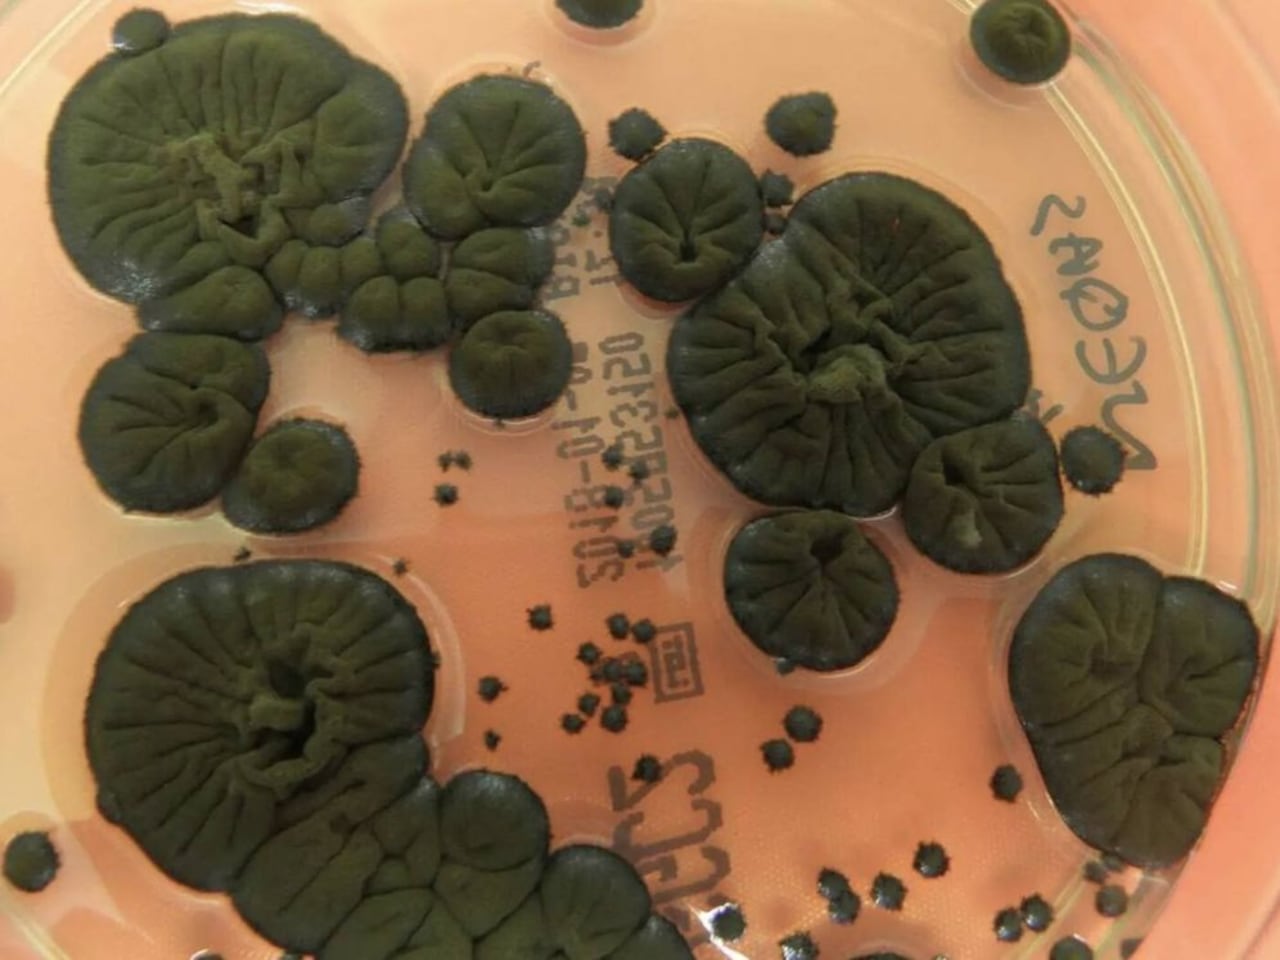
El hongo negro crece más bajo radiación, mostrando un aumento cercano al 10%.

Ciencia
Increíble noticia para la Nasa: un hongo del desastre de Chernóbil da una luz de esperanza al futuro de la humanidad
Cladosporium sphaerospermum crece incluso en las zonas más contaminadas del reactor.
Siga de cerca las tendencias en tecnología y ciencia en Discover

La Nasa ha identificado un hongo que podría transformar la manera en que la humanidad explora el espacio, ya que este organismo ofrecería formas de mejorar la protección y la seguridad de los astronautas durante sus misiones.
Un descubrimiento inesperado en las ruinas de Chernóbil
El proceso para descubrir este impresionante organismo comenzó en mayo de 1997 cuando la investigadora Nelli Zhdanova se adentró en lo que quedó de la central nuclear de Chernóbil, uno de los sitios más contaminados del planeta.
Entre techos, paredes y conductos cubiertos de polvo, la científica observó cómo un moho negro se había aferrado, algo que hasta entonces, se consideraba inhabitable.

El hallazgo no se limitó al interior del reactor, pues en los bosques y campos cercanos, la fauna regresaba con fuerza.
Animales cercanos se movían con libertad, algo que daba señal a que la vida puede adaptarse incluso en medio de la radiación, pero lo más sorprendente fue descubrir que los hongos no solo crecían alrededor de los restos contaminados, sino que se dirigían hacia las fuentes originales de radiación dentro del edificio del reactor.
Hongos que podrían proteger a los astronautas
El protagonista de esta historia es el hongo negro llamado Cladosporium sphaerospermum y su secreto se basa en la melanina, la cual responsable de los tonos de piel y cabello en los humanos.
En este moho, la melanina está concentrada en las paredes celulares, y al exponerse a la radiación, parece cambiar de forma, permitiendo que el hongo capture energía de manera similar a la fotosíntesis, un fenómeno que algunos expertos llaman radiosíntesis.
Estudios posteriores indicaron que al estar expuesto a radiación de ciertos elementos, como el cesio, el hongo mostró un aumento de crecimiento cercano al 10 %.
Motivados por este hallazgo, los científicos enviaron muestras del hongo Cladosporium sphaerospermum a la Estación Espacial Internacional, en donde fueron utilizados para que permanecieran varios meses bajo la constante radiación del espacio.
Los resultados señalaron que el hongo se desarrolló más rápido que sus equivalentes en la Tierra y además, parte de la radiación fue absorbida por su micelio, actuando como una especie de barrera protectora.
Nils Averesch, bioquímico de la Universidad de Florida y uno de los autores del estudio, advierte que los efectos protectores frente a la radiación observados en los hongos podrían estar relacionados con otros componentes biológicos, y no únicamente con la melanina.
Aunque aún falta confirmar si la protección se debe únicamente a la melanina o a otros componentes biológicos, los científicos ven un enorme potencial que podría servir como barrera contra la radiación en futuras misiones espaciales.
Cladosporium sphaerospermum ofrece un rayo de luz en la lucha contra los efectos de accidentes nucleares como el de Chernóbil, ocurrido el 26 de abril de 1986.

